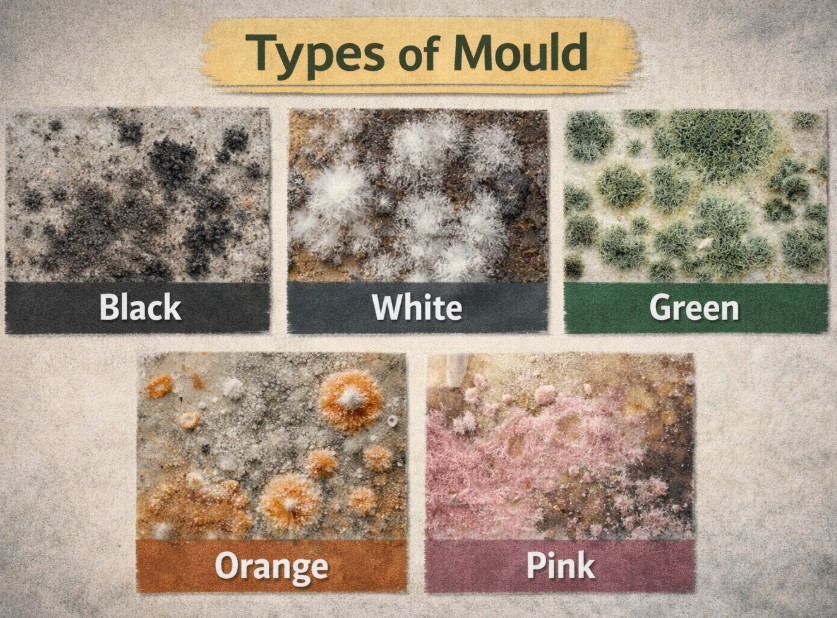

Most survey failures do not arise because a defect was missed entirely. They arise because something was seen, but not properly explained.
Damp and mould are a classic example. Many reports still include a brief line along the lines of “mould noted to bedroom wall – clean and improve ventilation”. From a distance, that can feel adequate. In practice, it often isn’t — and increasingly, it isn’t defensible.
The problem is not that the mould was overlooked. It is that the survey failed to explain why it matters, what it indicates, and what may happen if it is ignored. In today’s regulatory and legal climate, that gap is becoming harder to justify.
The context has changed — Whether we like it or not.
The Building Safety Act 2022 sits within a wider shift towards accountability, competence and risk-based decision-making in the built environment. While the Act is primarily focused on higher-risk buildings and life-safety themes such as fire and structural risk, the emphasis on competent judgement and foreseeable risk aligns with expectations increasingly applied across housing work more generally.
Surveyors cannot reasonably argue ignorance where a risk is well established, routinely encountered, and preventable. Damp and mould fall squarely into that category.
The expectation is no longer just “did you see it?” but “did you understand it, contextualise it, and advise proportionately?” Simply noting that mould exists, without meaningful interpretation, leaves too much unsaid — and places the surveyor in a weak position if outcomes later escalate.
A phrase still heard too often in practice is: “It’s only mould — The client can wipe it off.”
That mindset is not supported by building science, by the health evidence base, or by how mould behaves in occupied dwellings.
Mould is not a decorative defect. It is a symptom of moisture imbalance. Where moisture persists, mould recurrence is predictable. Where recurrence is predictable, risk is foreseeable.
Treating mould as a superficial cleanliness issue encourages cosmetic responses and repeated failure. From a reporting perspective, it also leads to vague advice that does not stand up to scrutiny.
This is not about writing an essay. It’s about making sure the client understands why it matters and what to do next, and that your reasoning is clear if the report is ever scrutinised.

One of the most common weaknesses in mould reporting is over-reliance on what happens to be visible at the time of inspection.
Effective inspection goes wider than that.
The absence of noticeable surface mould does not mean there is no risk. Historic staining, patchy redecoration, or faint discolouration can all indicate moisture conditions that remain active or readily recur.
Many surveyors are understandably cautious about commenting beyond what they can “prove”. This can lead to an over-focus on colour as a comfort blanket — if it’s black, it’s mould; if it isn’t, we hedge.
That approach misses the point.
Colour is not the key risk indicator. Duration, recurrence, and substrate involvement are.
These signs indicate that moisture is affecting the fabric, not just surface condensation. From a reporting perspective, they justify firmer language and clearer advice than a generic “clean and ventilate”.
Another common reporting weakness is treating ventilation as an afterthought — or assuming that the presence of a fan or trickle vent is equivalent to performance.
Ventilation and thermal context matter as much as staining, because they explain why mould is there and whether it will return.
A sentence such as “improve ventilation” without explaining the underlying moisture balance tells the client very little and offers the surveyor little protection.

Here is a simple but revealing training prompt:True or false: Orange mould exists in dwellings.
Some surveyors would instinctively answer false. That instinct exposes a broader issue.
Orange, rust-coloured or brownish growths and staining do occur in buildings, often associated with prolonged dampness affecting timber products, paper facings, adhesives or composite materials. They are not decorative anomalies and they are not imaginary.
The issue is not whether a surveyor can name the organism. It is whether an unusual appearance is recognised as a potential indicator of longer-term moisture exposure and material degradation.
Knowledge gaps matter because they shape confidence. When something does not fit the “black mould” mental model, it is more likely to be downplayed, dismissed, or vaguely described — precisely where a more straightforward explanation is needed.
A recurring problem in survey reports is the gap between identification and advice.
From a client’s perspective, this is unhelpful. From a professional-risk perspective, it is weak.
“Further investigation may be required” is not wrong — But it is incomplete unless framed properly.
How far should a surveyor go?
Surveyors are not expected to remediate mould, specify ventilation systems, or diagnose fungal species. But we are expected to join the dots competently.
What is no longer defensible is identifying mould and leaving the client to guess whether it matters.

Good mould advice is narrative, not alarmist.
“Mould growth on the external wall and window reveal of Bedroom 2 is consistent with sustained surface condensation at cold surfaces, likely exacerbated by restricted airflow and limited ventilation. While currently localised, recurrence is foreseeable unless underlying moisture and thermal conditions are addressed. Continued exposure may result in spread, fabric deterioration and ongoing indoor air quality concerns. Further assessment of ventilation performance and thermal risk is recommended, alongside removal of contaminated finishes and monitoring for recurrence.”
The second example does not overstep competence. It explains why, what may happen, and what should be done next. It is far easier to defend.
If further investigation is warranted, say what kind and why.
This framing shows that your recommendation is reasoned rather than generic.

The surveyor’s position, clearly stated.
Damp and mould are firmly within the surveyor’s professional territory. They are foreseeable, common, and rooted in building performance.
The expectation is not perfection. It is competence, clarity and proportionality.
Do that consistently, and your reports become not just safer but genuinely more useful to clients.
The author is a UK residential building surveyor and researcher focusing on practitioner-led approaches to damp and mould assessment, with particular emphasis on visual diagnosis, moisture behaviour and proportionate advice in domestic surveys. Current work includes the development of structured tools and guidance aimed at improving inspection consistency, reporting clarity and professional defensibility in mould-related cases.
Authored by
Mr kieran r. Mccoll, bsc (hons) building surveying & planning
Phd candidate, london south bank university
MRPSA, FNIBME, FISSE
Building Safety Act 2022 (c. 30). London: The stationery office.
Clark, A., Symonds, P., Colbourne, L. and Dimitroulopoulou, S. (2023) The burden of disease associated with exposure to damp and mould in England. London: UK Health Security Agency.
Fisk, W.J., Lei-Gomez, Q. and Mendell, M.J. (2010) ‘Meta-analyses of the associations of respiratory health effects with dampness and mould in homes’, Indoor Air, 20(4), pp. 284–296.
IEA EBC Annex 68 (2020) Indoor air quality design and control in low energy residential buildings. International Energy Agency, Energy in Buildings and Communities Programme.
Karvonen, A.M., Hyvärinen, A., Korppi, M., Putus, T., Nevalainen, A., Shaughnessy, R. and Haverinen-Shaughnessy, U. (2015) ‘Moisture damage and childhood asthma: a population-based incident case–control study’, European Respiratory Journal, 45(3), pp. 688–698.
McColl, K.R. (n.d.) A Practitioner-Led Visual Framework for Assessing Indoor Mould: Observable Behaviour, Progression, and the Proportionate Use of Laboratory Testing. Unpublished manuscript.
Mendell, M.J., Mirer, A.G., Cheung, K., Tong, M. and Douwes, J. (2011) ‘Respiratory and allergic health effects of dampness, mold, and dampness-related agents: a review of the epidemiologic evidence’, Environmental Health Perspectives, 119(6), pp. 748–756.
Menneer, T., Wingfield, J., Bell, M. and Elwell, C. (2022) ‘Long-term monitoring of indoor humidity and mould risk in UK dwellings’, Building and Environment, 207, Article 108463.
Thacher, J.D., Gruzieva, O., Pershagen, G., Neuman, Å., Wickman, M., Kull, I. and Melén, E. (2017) ‘Pre- and postnatal exposure to dampness and mould and development of asthma to age 16 years’, Environmental Health Perspectives, 125(1), pp. 127–133.
World Health Organisation (WHO) (2009) WHO guidelines for indoor air quality: dampness and mould. Copenhagen: WHO Regional Office for Europe.